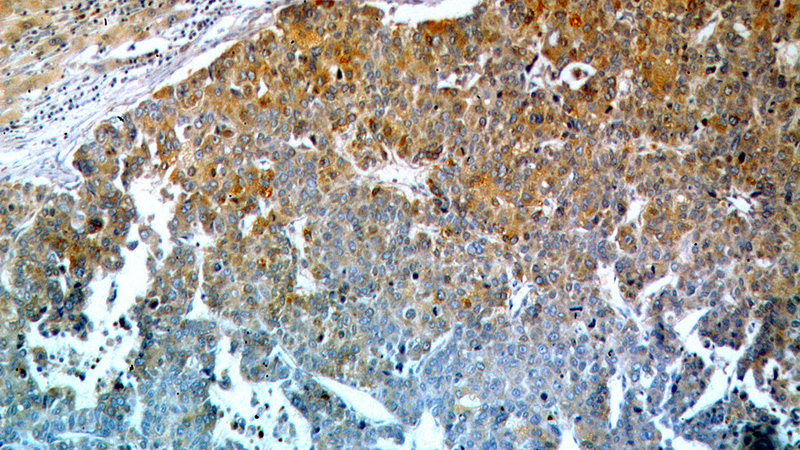
Immunohistochemical of paraffin-embedded human liver cancer using Catalog No:114425(RAB27A antibody) at dilution of 1:100 (under 10x lens)

-
Product Name
RAB27A antibody
- Documents
-
Description
RAB27A Rabbit Polyclonal antibody. Positive WB detected in HL-60 cells, Apoptosised HeLa cells, HeLa cells, human liver tissue, Jurkat cells, K-562 cells, L02 cells. Positive IP detected in K-562 cells. Positive IF detected in HepG2 cells. Positive IHC detected in human liver cancer tissue, human kidney tissue. Observed molecular weight by Western-blot: 25-27 kDa
-
Tested applications
ELISA, WB, IHC, IF, IP
-
Species reactivity
Human; other species not tested.
-
Alternative names
GS2 antibody; GTP binding protein Ram antibody; HsT18676 antibody; Rab 27 antibody; RAB27 antibody; RAB27A antibody; RAM antibody; Ras related protein Rab 27A antibody
- Immunogen
-
Isotype
Rabbit IgG
-
Preparation
This antibody was obtained by immunization of RAB27A recombinant protein (Accession Number: XM_011521855). Purification method: Antigen affinity purified.
-
Clonality
Polyclonal
-
Formulation
PBS with 0.02% sodium azide and 50% glycerol pH 7.3.
-
Storage instructions
Store at -20℃. DO NOT ALIQUOT
-
Applications
Recommended Dilution:
WB: 1:500-1:5000
IP: 1:500-1:5000
IHC: 1:20-1:200
IF: 1:10-1:100
-
Validations

HL-60 cells were subjected to SDS PAGE followed by western blot with Catalog No:114425(RAB27A antibody) at dilution of 1:1000
Immunohistochemical of paraffin-embedded human liver cancer using Catalog No:114425(RAB27A antibody) at dilution of 1:100 (under 10x lens)

Immunohistochemical of paraffin-embedded human liver cancer using Catalog No:114425(RAB27A antibody) at dilution of 1:100 (under 40x lens)

Immunofluorescent analysis of HepG2 cells, using RAB27A antibody Catalog No:114425 at 1:25 dilution and Rhodamine-labeled goat anti-rabbit IgG (red).

IP Result of anti-RAB27A (IP:Catalog No:114425, 4ug; Detection:Catalog No:114425 1:1000) with K-562 cells lysate 3200ug.
-
Background
Rab27a is a member of a large family of Ras-related small GTPases. The protein is membrane-bound and may be involved in protein transport and small GTPase mediated signal transduction. Recent studies suggest that Rab27a is associated with melanosomes in pigmented cells and regulates melanosome transport via its interaction with actin-based cellular motors such as myosin Va and myosin VIIa. RAB27A is also required for regulated secretion in cytotoxic T lymphocytes. Rab27a is implicated in several diseases, including Griscelli syndrome, choroideremia, and the Hermansky-Pudlak syndrome mouse model, gunmetal.
-
References
- Shin SJ, Smith JA, Rezniczek GA. Unexpected gain of function for the scaffolding protein plectin due to mislocalization in pancreatic cancer. Proceedings of the National Academy of Sciences of the United States of America. 110(48):19414-9. 2013.
- Asano S, Nemoto T, Kitayama T. Phospholipase C-related catalytically inactive protein (PRIP) controls KIF5B-mediated insulin secretion. Biology open. 3(6):463-74. 2014.
- Gomi H, Morikawa S, Shinmura N. Expression of Secretogranin III in Chicken Endocrine Cells: Its Relevance to the Secretory Granule Properties of Peptide Prohormone Processing and Bioactive Amine Content. The journal of histochemistry and cytochemistry : official journal of the Histochemistry Society. 63(5):350-66. 2015.
- Wang HH, Cui Q, Zhang T. Rab3A, Rab27A, and Rab35 regulate different events during mouse oocyte meiotic maturation and activation. Histochemistry and cell biology. 2016.
- Gao N, Kaestner KH. Cdx2 regulates endo-lysosomal function and epithelial cell polarity. Genes & development. 24(12):1295-305. 2010.
- Rendón WO, Martínez-Alonso E, Tomás M, Martínez-Martínez N, Martínez-Menárguez JA. Golgi fragmentation is Rab and SNARE dependent in cellular models of Parkinson's disease. Histochemistry and cell biology. 139(5):671-84. 2013.
- Li J, Liu K, Liu Y. Exosomes mediate the cell-to-cell transmission of IFN-α-induced antiviral activity. Nature immunology. 14(8):793-803. 2013.
Related Products / Services
Please note: All products are "FOR RESEARCH USE ONLY AND ARE NOT INTENDED FOR DIAGNOSTIC OR THERAPEUTIC USE"
